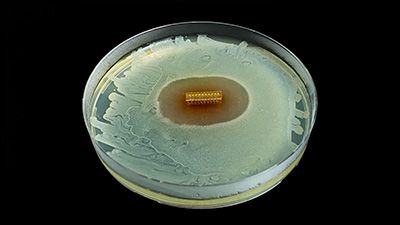
HydroShield™ Coating

-
Rigi10™ is the new malleable penile prosthesis from Rigicon. The Rigi10™ offers physicians a malleable penile prosthesis that is easy to size, extend, and implant.
-
The Rigi10™ is designed to offer the patient a durable treatment option that can provide the required rigidity, comfort, and discretion.
-
The Rigi10™ is a unique combination of Rigicon’s experience in men’s health and the cutting edge advancements in medical technology.
Easy to Implant
HydroShield™ Coating
Rigi10™ incorporates a hydrophilic coating on the device surface, including the rear tip extenders. HydroShield™ hydrophilic coating will give the surgeon the freedom to choose for the dipping solution and may promote easier device implantation.2

Optimal size-based options
The Rigi10™ Malleable Penile Prosthesis is available in 9 – 10 – 11 – 12 – 13 mm diameters and lengths of 23 cm (9 and 10 mm) and 25 cm (11, 12 and 13 mm). There is no sure way to determine the size of the penile anatomy before the surgery. Diverse sizing options with Rigi10™ facilitates a surgeon-made fit to the patient.
Rigi10™ At A Glance


Soft-to-touch tip
Soft-to-touch distal tip gives the patient a comfortable feel during daily activities.

Angled tip

HydroShield™ Coating

HydroShield™ Coating

Rigidity

Rigidity

Flexible Rod Technology™

Flexible Rod Technology™

SecureFit™ RTE

SecureFit™ RTE
SecureFit™ Extenders
Rigid

Durable
Rigi10™ rods are cycled from 0 to 90° bend for repeated cycles without mechanical failure to demonstrate durability in the long term.8

Flexible Rod Technology™
Learn more about Erectile Dysfunction and find resources to help you understand your treatments options at www.malleablepenileprosthesis.com
References
FAQ
What is erectile dysfunction (ED)?
Previously known as impotence, erectile dysfunction (ED) refers to the inability to achieve and maintain an erection sufficient for sexual intercourse. It is unrelated to sexual desire, libido, ejaculation, or pleasure. ED is solely concerned with the ability to achieve adequate penile stiffness for engaging in sexual activity.
What is a penile prosthesis?
A penile prosthesis is a sterile device implanted in men to provide sufficient penile rigidity for sexual penetration. There are two types:
- Malleable semi-rigid rods, inserted through a small penile incision. Flexible wires allow the device to be straight for penetration or curved for concealment.
- Inflatable penile prosthesis, which provides stiffness and increased girth by pumping saline into balloon-like structures implanted in the penis’ erectile chambers. Currently, only three-piece models are available, as they offer the best results for erection and flaccidity.
Can someone who views me without clothing know that I have a penile prosthesis?
No, the device is invisible when integrated into the genitalia.
How long will my erection last with a penile prosthesis?
Your erection is on-demand and can be maintained for as long as you desire. Flaccidity is also under your control.
Will I have an orgasm with a penile prosthesis?
The penile implant does not impact orgasm or ejaculation. These events occur following sexual excitement. If you could achieve orgasm or ejaculation before the penile implant surgery, you should be able to do so afterward.
Can I impregnate a woman with a penile prosthesis?
Yes, if the woman is fertile and you have not undergone sterilization, sex with a penile implant can result in pregnancy. Many young men with diabetes seek penile implant surgery to restore their ability to father a child.
Can I have an imaging procedure called MRI with a penile implant?
Yes, all penile implant devices are MR Conditional, meaning you can be safely scanned. Manufacturers provide special instructions for those with a penile implant requiring an MRI scan.
What are the benefits of a Rigicon Rigi10™ when compared to an inflatable penile implant?
The Rigicon Rigi10™ malleable device is more affordable, simpler, and less likely to require revision surgery due to malfunction or medical issues. The surgery and recovery time are shorter compared to inflatable penile implants. It is the preferred choice for patients with limited manual dexterity.
What is Rigi10™’s Flexible Rod Technology™?
Rigi10™ malleable prostheses feature cutting-edge Flexible Rod Technology™, offering a high bending angle of ≥130º. This high bending angle makes the surgery easier for the surgeon and provides better concealability for the patient.